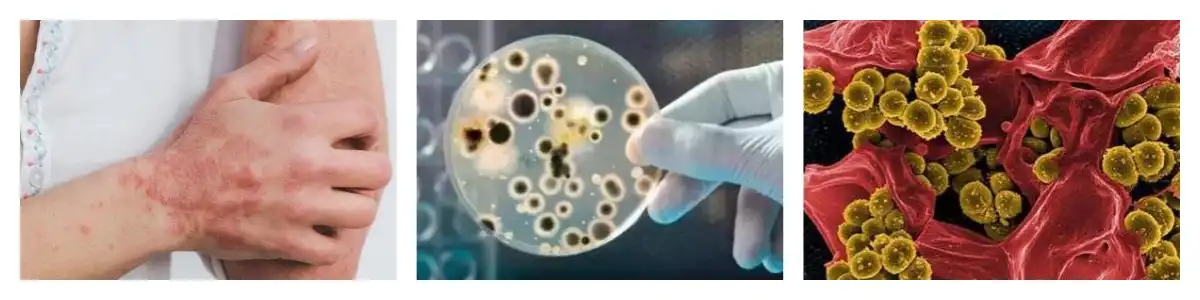
product-1-1 product-1-1

Allicin Garlic Extract
Appearance:Light Yellow Fine Powder
Specification:Raw Powder; 10:1;1%-10%
Partial Size:98% Pass 80 Mesh
Shelf Life:2 Years
Sample:10-20g
Storage:Cool Dry Place
MOQ:1 Kg
Allicin Garlic Extract: Product Introduction
Our allicin garlic extract is a natural product of high quality made from garlic.It is an intense wellspring of allicin, a compound with an extensive variety of medical advantages. You will receive a dependable ingredient that can be used in a variety of applications because our extract has been carefully processed to ensure the highest purity and potency.
Garlic Extract Allicin Powder is a natural dietary supplement that is derived from the garlic herb. Allicin is the main active and beneficial compound present in garlic. It is formed when two enzymes, alliin and allinase, come into contact with each other. Allicin is well-known for its antioxidant, antimicrobial, anti-inflammatory, and immune-boosting properties.

Specifications of Allicin Garlic Extract
| Specification | Details |
|---|---|
| Product name | Garlic Extract |
| Active Ingredient | Garlicin , Allicin |
| Specifications | Raw Powder; 10:1;1%-10% |
| Test method | HPLC |
| Appearance | Light Yellow Fine Powder |
| Partial Size | 98% Pass 80 Mesh |
| MOQ | 1 Kg |
| Packaging |
For 0.5kgs to 5kgs, Aluminum foil bags + Aseptic bag vacuum packaging For 25kgs, double-layer Aseptic bag + Paper Drums |
| Shelf Life | 2 years under proper storage |
| Storage Conditions | Cool, dry place away from light |
Functions of Allicin Garlic Extract
1.It have strong antibacterial and anti-inflammatory effects, and Allicin can inhibit or kill a variety of cocci, bacilli, fungi and viruses.
2.It have a variety of pathogenic bacteria such as staphylococcus, meningitis, pneumococcus, streptococcus and diphtheria, dysentery, escherichia coli, typhoid, paratyphoid, pertussis, tuberculosis bacillus and vibrio cholerae have obvious inhibition or killing effect.
3.It can treat acute bacillary dysentery, whooping cough, infantile diarrhea, lobar pneumonia, tuberculosis, wound fester, trachoma and so on.
4.It turns out by the antibacterial principle of Allicin that the oxygen atoms in the Allicin molecule combine with the mercapto group in the cysteine molecule which is necessary for the growth and reproduction of bacteria and inhibit the growth and reproduction of bacteria.
5.It is widely used to prevent kinds of infections, prohibit and kill harmful germs and improve animals’ immunization, disease resistance and stress resistance. Garlic extract allicin powder has a comparatively prevention effect for some diseases caused by various infections, such as red skin, enteritis and bleeding for fish, shrimp and crab.
Application Areas of Allicin Garlic Extract
1.It is suitable for poultry, fish, shimp,crab and turtle.
2.It is applied in animals as medicine and food supplements.
3.It is applied in the field pharmaceuticals.
4.It is applied in the field of healthcare products as nutritionsupplements.
5.It is applied in the field of food as additive.


Packing
For powder products, we usually send the products together with cartons or fiber drums.For liquid products, we usually send the product together with a plastic.

Our packaging methods are 1 kg/aluminum bag, 25 kg/box, and 25 kg/barrel. For some products that require special packaging during transportation, we will carry out more detailed packaging.

Transportation
We support shipping by air, sea, FedEx, DHL, TNT, EMS, UPS, SF, and other carrier.

Our laboratory and Factory
As a professional plant extract supplier, our quality inspection department is equipped with the most advanced testing and identification instruments, such as UPLC, HPLC, UV and TT (active ingredients) GC and GC-MS (solvent residue), ICP-MS ( Heavy metals), GC/LC-MS-MS (pesticide residues), HPTLC and IR (identification), ELIASA (ORAC value), PPSL (irradiation residues), microbial detection, etc.

Application
There are various types of plant extracts, and their functions are also diverse. An extract often has different functions and is mainly used for coloring, flavor output, pharmacological effects and health care functions.

About us
Shaanxi Rebecca Bio-Tech Co.,LTD, specializes in Research&Production on plant extracts, isolation of active ingredients of traditional Chinese medicine and functional compound formulations of traditional Chinese medicine. We have a high-quality technical R&D team with strong technical force, many experienced R&D personnel, an excellent marketing team and domestic regional channel partners. We specialize in product market development and product after-sales service, and are committed to serving customers all over the world. We provide high-quality natural herbal extracts to customers in the pharmaceutical, health care products, beverages, cosmetics and other industries.
At Rebecca, we follow market development trends and actively develop innovative products on the premise of continuity and diversity of herbal medicines. We believe that natural specialty ingredients and innovative technologies are the best basis for us to meet our customers' needs. There are other related high-quality products under our main categories, and we also support customized services.
Contact us:
To view our brochure or discuss a bulk order, contact us at information@sxrebecca.com.








